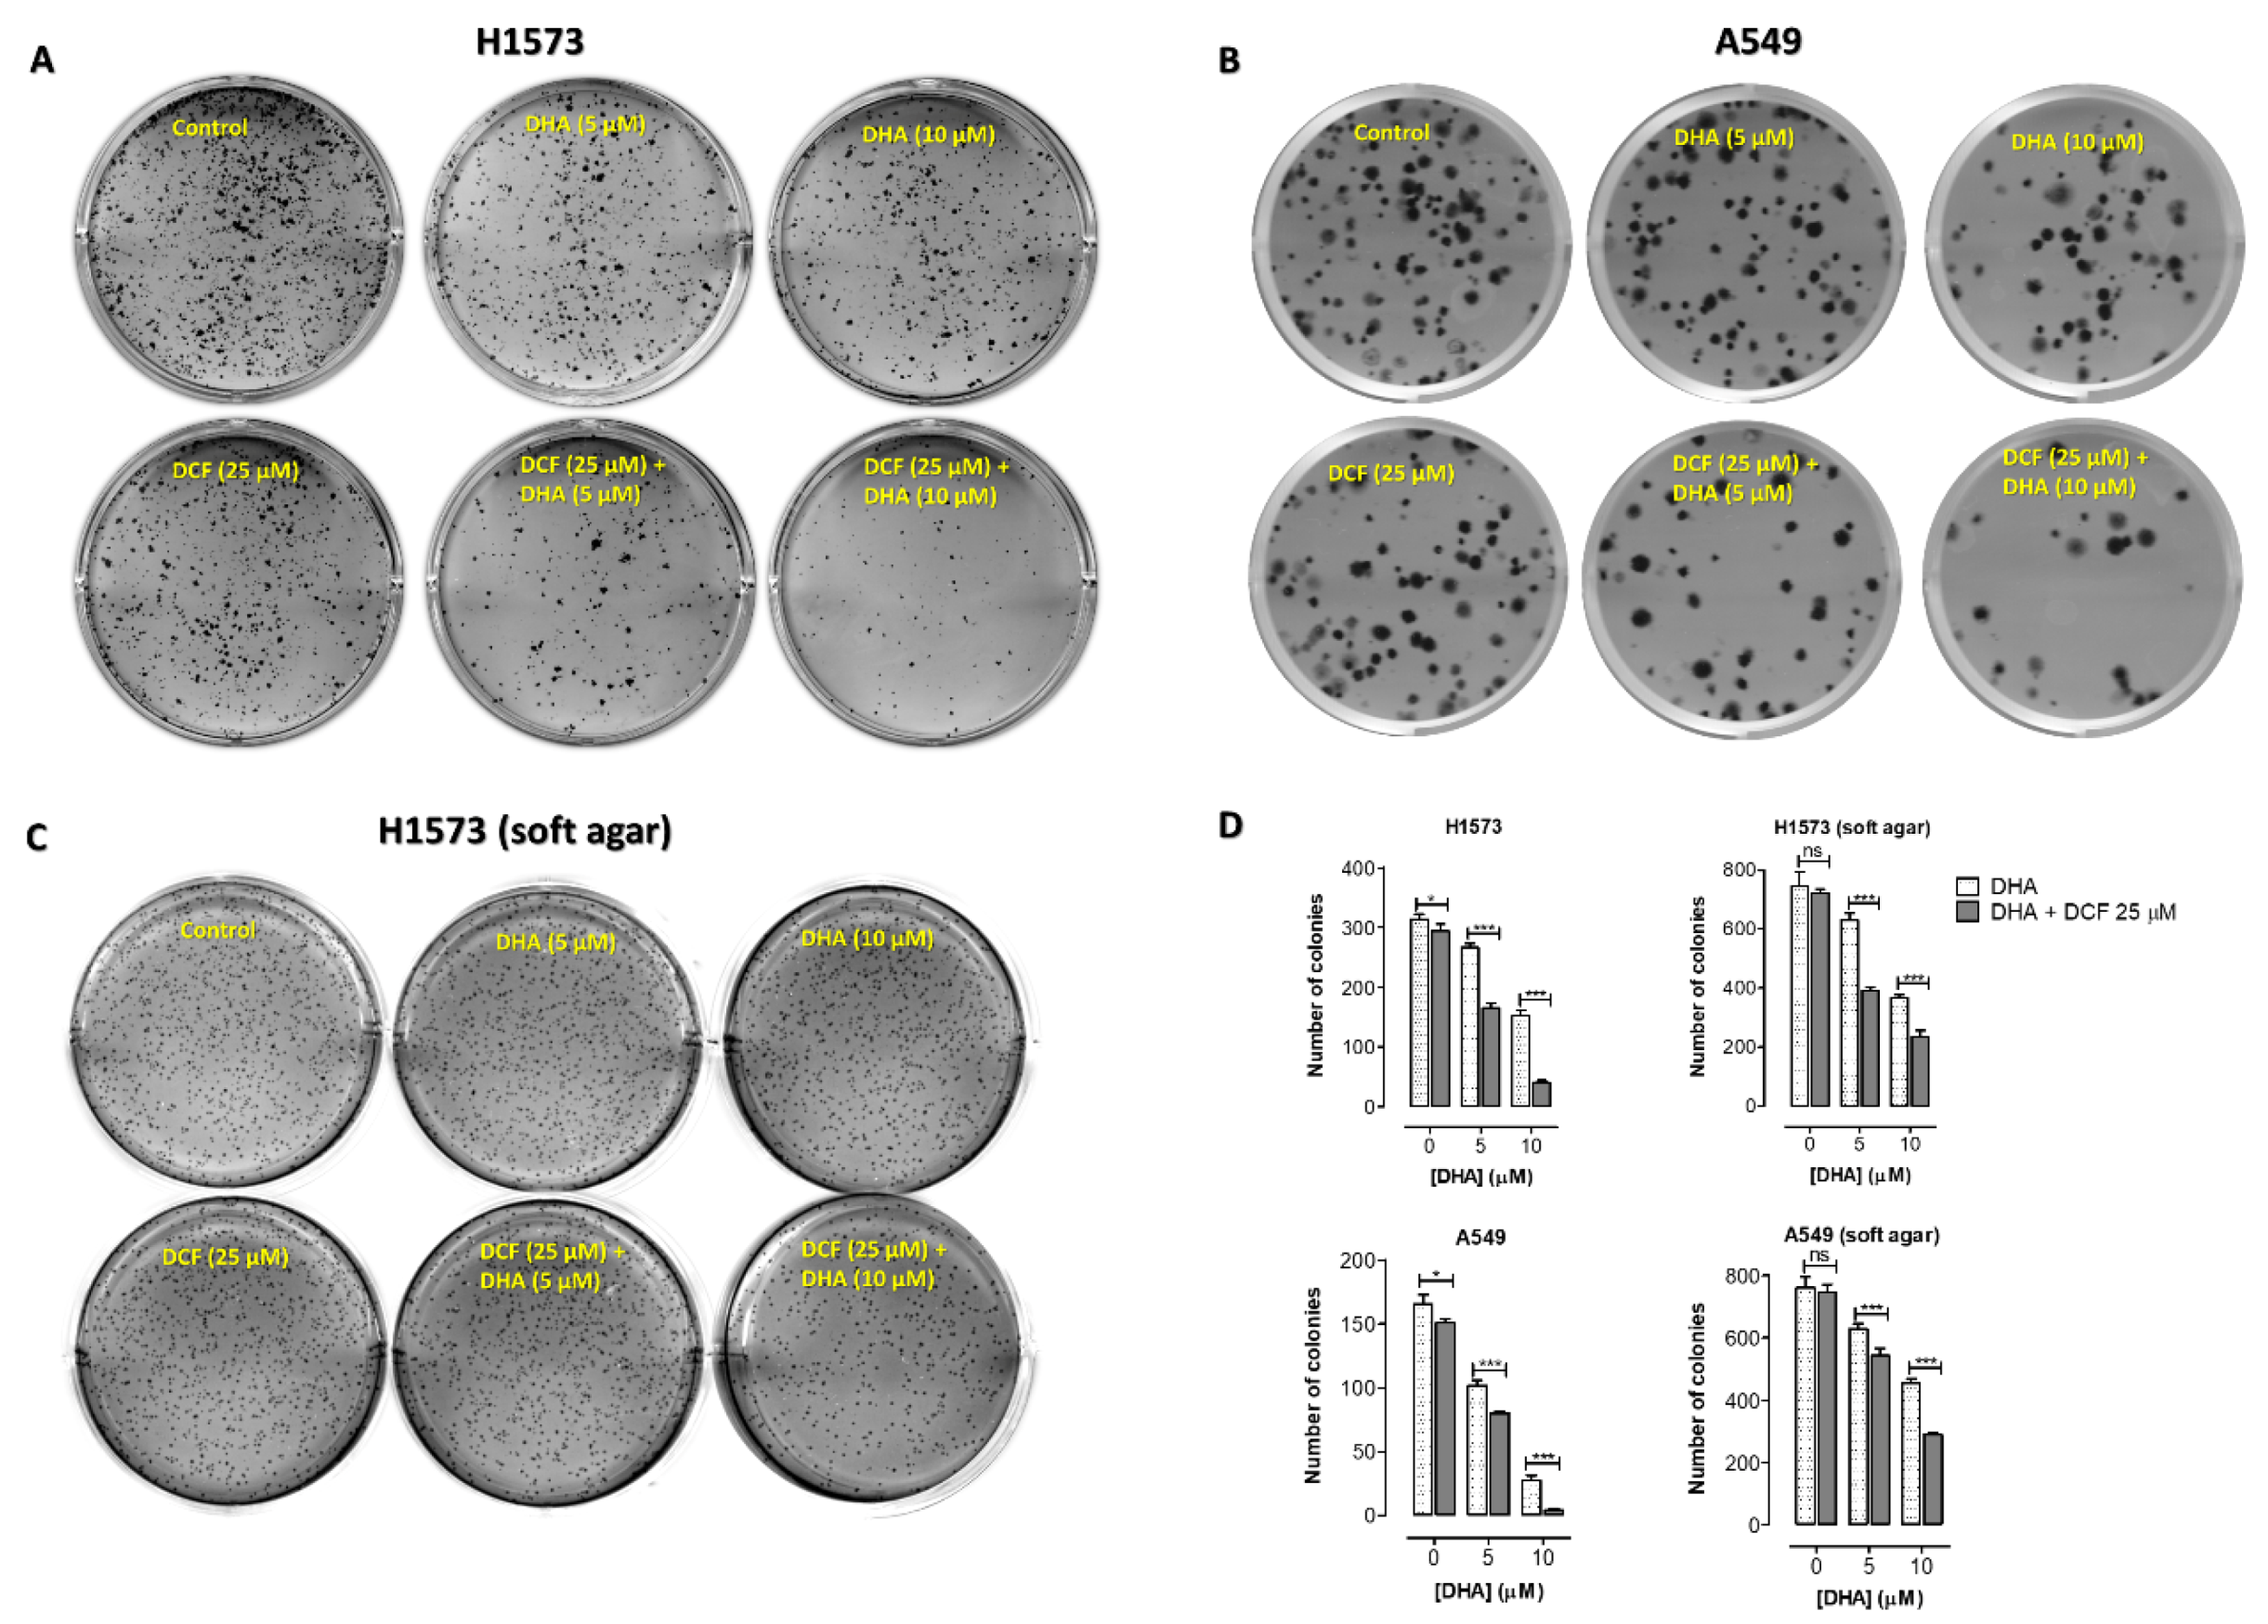
Cancers 12 02683 g004

Diclofenac Enhances Docosahexaenoic Acid-Induced Apoptosis in Vitro in Lung Cancer Cells
Simple Summary
Abstract
1. Introduction
2. Results
2.1. Co-Treatment of Lung Cancer Cells with NSAIDs and DHA Enhanced Cytotoxicity
2.2. Co-Treatment of Lung Cancer Cells with DHA and Diclofenac Decreased Clonogenic Cell Survival
2.3. Co-Treatment of Lung Cancer Cells with DHA and Diclofenac Induces Apoptosis
2.4. Co-Treatment of Lung Cancer Cells with DHA and Diclofenac Altered Expression of Cancer-Related Proteins in A549 and NCI-H1573 Cells
2.5. Co-Treatment of Lung Cancer Cells with DHA and Diclofenac Inhibits the Ras/MEK/ERK and PI3K/AKT Signaling Pathways
3. Discussion
4. Materials and Methods
4.1. Materials and Reagents
4.2. Cell Lines
4.3. Cell Viability Assay
4.4. Cell Apoptosis Assays
4.4.1. Acridine Orange/Ethidium Bromide (AO/EB) Double Staining Assay
4.4.2. Annexin-V-FITC Assay
4.4.3. Caspase-3/7 in situ Assay
4.5. Clonogenic Cell Survival and Anchorage-Independent Growth Assays
4.6. Effects of DHA with Diclofenac on the Expression of Cancer-Related Genes
4.7. Immunoblotting
RAS Pull-Down Assay
4.8. Statistical Analysis
5. Conclusions
Supplementary Materials
Author Contributions
Funding
Acknowledgments
Conflicts of Interest
Abbreviations
| DHA | docosahexaenoic acid |
| EPA | eicosapentaenoic acid |
| COX | cyclooxygenase |
| NSCLC | non-small cell lung cancer |
| NSAIDs | non-steroidal anti-inflammatory drugs |
| DCF | diclofenac |
| PUFAs | polyunsaturated fatty acids |
| PGs | prostaglandins |
| CI | combination index |
| GTPase | nucleotide guanosine triphosphate hydrolase |
| NFκB | nuclear factor kappa-light-chain-enhancer of activated B |
| TGF-β | transforming growth factor beta |
| MEK | mitogen-activated protein kinase/extracellular signal-regulated kinase |
| ERK | extracellular signal-regulated kinase |
| PPARs | peroxisome proliferator-activated receptors |
| MAPK | mitogen-activated protein kinase |
| PI3K | phosphoinositide 3-kinase |
| Akt | protein kinase B |
| mTOR | mammalian target of rapamycin |
| JAK | janus kinase |
| STAT | signal transducer and activator of transcription |
| FITC | fluorescein isothiocyanate |
| RIPA | radioimmunoprecipitation assay |
| BCA | bicinchoninic acid assay |
| GADD45A | growth arrest and DNA damage-inducible alpha |
| TNFAIP3 | tumor necrosis factor alpha-induced protein 3 |
| CDC25C | M-phase inducer phosphatase 3 |
| E2F1 | transcription factor |
| PCNA | proliferating cell nuclear antigen |
| CCNA2 | cyclin-A2 |
| CCNB1 | G2/mitotic-specific cyclin-B1 |
| CCNE2 | cyclin E2 |
| HDAC2 | histone deacetylase 2 |
| POLE2 | DNA polymerase epsilon subunit 2 |
| UBE2T | ubiquitin-conjugating enzyme |
| HIST1H3B | histone H3.1 |
| CDKN2C | cyclin-dependent kinase 4 inhibitor C |
References
- Siegel, R.L.; Miller, K.D.; Jemal, A. Cancer statistics, 2020. Ca: A Cancer J. Clin. 2020, 70, 7–30. [Google Scholar] [CrossRef] [PubMed]
- Keith, R.L.; Miller, Y.E. Lung cancer chemoprevention: Current status and future prospects. Nat. Rev. Clin. Oncol. 2013, 10, 334–343. [Google Scholar] [CrossRef] [PubMed]
- Sporn, M.B. Approaches to prevention of epithelial cancer during the preneoplastic period. Cancer Res. 1976, 36, 2699–2702. [Google Scholar]
- Hua, H.; Zhang, H.; Kong, Q.; Wang, J.; Jiang, Y. Complex roles of the old drug aspirin in cancer chemoprevention and therapy. Med. Res. Rev. 2019, 39, 114–145. [Google Scholar] [CrossRef]
- D’Eliseo, D.; Velotti, F. Omega-3 Fatty Acids and Cancer Cell Cytotoxicity: Implications for Multi-Targeted Cancer Therapy. J. Clin. Med. 2016, 5, 15. [Google Scholar] [CrossRef] [PubMed]
- Seewaldt, V.L. Aspirin and Chemoprevention-Have We Arrived? JAMA Oncol. 2018, 4, 1668–1669. [Google Scholar] [CrossRef]
- Harizi, H.; Corcuff, J.B.; Gualde, N. Arachidonic-acid-derived eicosanoids: Roles in biology and immunopathology. Trends Mol. Med. 2008, 14, 461–469. [Google Scholar] [CrossRef]
- Marnett, L.J. The COXIB experience: A look in the rearview mirror. Annu. Rev. Pharmacol. Toxicol. 2009, 49, 265–290. [Google Scholar] [CrossRef]
- Greenhough, A.; Smartt, H.J.; Moore, A.E.; Roberts, H.R.; Williams, A.C.; Paraskeva, C.; Kaidi, A. The COX-2/PGE2 pathway: Key roles in the hallmarks of cancer and adaptation to the tumour microenvironment. Carcinogenesis 2009, 30, 377–386. [Google Scholar] [CrossRef]
- Yang, P.; Cartwright, C.; Chan, D.; Ding, J.; Felix, E.; Pan, Y.; Pang, J.; Rhea, P.; Block, K.; Fischer, S.M.; et al. Anticancer activity of fish oils against human lung cancer is associated with changes in formation of PGE2 and PGE3 and alteration of Akt phosphorylation. Mol. Carcinog. 2014, 53, 566–577. [Google Scholar] [CrossRef]
- Umar, A.; Steele, V.E.; Menter, D.G.; Hawk, E.T. Mechanisms of nonsteroidal anti-inflammatory drugs in cancer prevention. Semin. Oncol. 2016, 43, 65–77. [Google Scholar] [CrossRef] [PubMed]
- Rothwell, P.M.; Wilson, M.; Elwin, C.E.; Norrving, B.; Algra, A.; Warlow, C.P.; Meade, T.W. Long-term effect of aspirin on colorectal cancer incidence and mortality: 20-year follow-up of five randomised trials. Lancet 2010, 376, 1741–1750. [Google Scholar] [CrossRef]
- Petrera, M.; Paleari, L.; Clavarezza, M.; Puntoni, M.; Caviglia, S.; Briata, I.M.; Oppezzi, M.; Mislej, E.M.; Stabuc, B.; Gnant, M.; et al. The ASAMET trial: A randomized, phase II, double-blind, placebo-controlled, multicenter, 2 x 2 factorial biomarker study of tertiary prevention with low-dose aspirin and metformin in stage I-III colorectal cancer patients. BMC Cancer 2018, 18, 1210. [Google Scholar] [CrossRef] [PubMed]
- Pan, Y.; Jiang, Y.; Tan, L.; Ravoori, M.K.; Gagea, M.; Kundra, V.; Fischer, S.M.; Yang, P. Deletion of cyclooxygenase-2 inhibits K-ras-induced lung carcinogenesis. Oncotarget 2015, 6, 38816–38826. [Google Scholar] [CrossRef] [PubMed]
- Arisan, E.D.; Ergul, Z.; Bozdag, G.; Rencuzogullari, O.; Coker-Gurkan, A.; Obakan-Yerlikaya, P.; Coskun, D.; Palavan-Unsal, N. Diclofenac induced apoptosis via altering PI3K/Akt/MAPK signaling axis in HCT 116 more efficiently compared to SW480 colon cancer cells. Mol. Biol. Rep. 2018, 45, 2175–2184. [Google Scholar] [CrossRef] [PubMed]
- Pantziarka, P.; Sukhatme, V.; Bouche, G.; Meheus, L.; Sukhatme, V.P. Repurposing Drugs in Oncology (ReDO)-diclofenac as an anti-cancer agent. Ecancermedicalscience 2016, 10, 610. [Google Scholar] [CrossRef]
- Tomic, T.; Dominguez-Lopez, S.; Barrios-Rodriguez, R. Non-aspirin non-steroidal anti-inflammatory drugs in prevention of colorectal cancer in people aged 40 or older: A systematic review and meta-analysis. Cancer Epidemiol. 2018, 58, 52–62. [Google Scholar] [CrossRef]
- Patrignani, P.; Patrono, C. Aspirin, platelet inhibition and cancer prevention. Platelets 2018, 29, 779–785. [Google Scholar] [CrossRef]
- Saini, K.S.; Loi, S.; de Azambuja, E.; Metzger-Filho, O.; Saini, M.L.; Ignatiadis, M.; Dancey, J.E.; Piccart-Gebhart, M.J. Targeting the PI3K/AKT/mTOR and Raf/MEK/ERK pathways in the treatment of breast cancer. Cancer Treat. Rev. 2013, 39, 935–946. [Google Scholar] [CrossRef]
- Moreira, L.; Castells, A. Cyclooxygenase as a target for colorectal cancer chemoprevention. Curr. Drug Targets 2011, 12, 1888–1894. [Google Scholar] [CrossRef]
- Liggett, J.L.; Zhang, X.; Eling, T.E.; Baek, S.J. Anti-tumor activity of non-steroidal anti-inflammatory drugs: Cyclooxygenase-independent targets. Cancer Lett. 2014, 346, 217–224. [Google Scholar] [CrossRef] [PubMed]
- Fink, S.P.; Dawson, D.M.; Zhang, Y.; Kresak, A.; Lawrence, E.G.; Yang, P.; Chen, Y.; Barnholtz-Sloan, J.S.; Willis, J.E.; Kopelovich, L.; et al. Sulindac reversal of 15-PGDH-mediated resistance to colon tumor chemoprevention with NSAIDs. Carcinogenesis 2015, 36, 291–298. [Google Scholar] [CrossRef] [PubMed]
- Setia, S.; Sanyal, S.N. Upregulation of intrinsic apoptotic pathway in NSAIDs mediated chemoprevention of experimental lung carcinogenesis. Pharmacol. Rep. Pr. 2012, 64, 615–624. [Google Scholar] [CrossRef]
- Berquin, I.M.; Edwards, I.J.; Chen, Y.Q. Multi-targeted therapy of cancer by omega-3 fatty acids. Cancer Lett. 2008, 269, 363–377. [Google Scholar] [CrossRef]
- Toit-Kohn, J.L.; Louw, L.; Engelbrecht, A.M. Docosahexaenoic acid induces apoptosis in colorectal carcinoma cells by modulating the PI3 kinase and p38 MAPK pathways. J. Nutr. Biochem. 2009, 20, 106–114. [Google Scholar] [CrossRef]
- Amissah, F.; Taylor, S.; Duverna, R.; Ayuk-Takem, L.T.; Lamango, N.S. Regulation of polyisoprenylated methylated protein methyl esterase by polyunsaturated fatty acids and prostaglandins. Eur. J. Lipid Sci. Technol. 2011, 113, 1321–1331. [Google Scholar] [CrossRef]
- Sam, M.R.; Tavakoli-Mehr, M.; Safaralizadeh, R. Omega-3 fatty acid DHA modulates p53, survivin, and microRNA-16-1 expression in KRAS-mutant colorectal cancer stem-like cells. Genes Nutr. 2018, 13, 8. [Google Scholar] [CrossRef]
- Newell, M.; Baker, K.; Postovit, L.M.; Field, C.J. A Critical Review on the Effect of Docosahexaenoic Acid (DHA) on Cancer Cell Cycle Progression. Int. J. Mol. Sci. 2017, 18, 1784. [Google Scholar] [CrossRef]
- Fukui, M.; Kang, K.S.; Okada, K.; Zhu, B.T. EPA, an omega-3 fatty acid, induces apoptosis in human pancreatic cancer cells: Role of ROS accumulation, caspase-8 activation, and autophagy induction. J. Cell. Biochem. 2013, 114, 192–203. [Google Scholar] [CrossRef]
- Yin, Y.; Sui, C.; Meng, F.; Ma, P.; Jiang, Y. The omega-3 polyunsaturated fatty acid docosahexaenoic acid inhibits proliferation and progression of non-small cell lung cancer cells through the reactive oxygen species-mediated inactivation of the PI3K /Akt pathway. Lipids Health Dis. 2017, 16, 87. [Google Scholar] [CrossRef]
- Kafrawy, O.; Zerouga, M.; Stillwell, W.; Jenski, L.J. Docosahexaenoic acid in phosphatidylcholine mediates cytotoxicity more effectively than other omega-3 and omega-6 fatty acids. Cancer Lett. 1998, 132, 23–29. [Google Scholar] [CrossRef]
- Guieze, R.; Gyan, E.; Tournilhac, O.; Halty, C.; Veyrat-Masson, R.; Akil, S.; Berger, M.; Herault, O.; Callanan, M.; Bay, J.O. Docosahexaenoic Acid Induces Apoptosis in Primary Chronic Lymphocytic Leukemia Cells. Hematol. Rep. 2015, 7, 6043. [Google Scholar] [CrossRef] [PubMed]
- Merendino, N.; Costantini, L.; Manzi, L.; Molinari, R.; D’Eliseo, D.; Velotti, F. Dietary omega -3 polyunsaturated fatty acid DHA: A potential adjuvant in the treatment of cancer. Biomed. Res. Int. 2013, 2013, 310186. [Google Scholar] [CrossRef] [PubMed]
- Warner, T.D.; Giuliano, F.; Vojnovic, I.; Bukasa, A.; Mitchell, J.A.; Vane, J.R. Nonsteroid drug selectivities for cyclo-oxygenase-1 rather than cyclo-oxygenase-2 are associated with human gastrointestinal toxicity: A full in vitro analysis. Proc. Natl. Acad. Sci. USA 1999, 96, 7563–7568. [Google Scholar] [CrossRef]
- Altman, R.; Bosch, B.; Brune, K.; Patrignani, P.; Young, C. Advances in NSAID development: Evolution of diclofenac products using pharmaceutical technology. Drugs 2015, 75, 859–877. [Google Scholar] [CrossRef]
- Yoon, S.; Park, S.J.; Han, J.H.; Kang, J.H.; Kim, J.H.; Lee, J.; Park, S.; Shin, H.J.; Kim, K.; Yun, M.; et al. Caspase-dependent cell death-associated release of nucleosome and damage-associated molecular patterns. Cell Death Dis. 2014, 5, e1494. [Google Scholar] [CrossRef]
- Wiesweg, M.; Kasper, S.; Worm, K.; Herold, T.; Reis, H.; Sara, L.; Metzenmacher, M.; Abendroth, A.; Darwiche, K.; Aigner, C.; et al. Impact of RAS mutation subtype on clinical outcome-a cross-entity comparison of patients with advanced non-small cell lung cancer and colorectal cancer. Oncogene 2019, 38, 2953–2966. [Google Scholar] [CrossRef]
- Stephen, A.G.; Esposito, D.; Bagni, R.K.; McCormick, F. Dragging ras back in the ring. Cancer Cell 2014, 25, 272–281. [Google Scholar] [CrossRef]
- Amissah, F.; Poku, R.A.; Aguilar, B.J.; Duverna, R.; Abonyo, B.O.; Lamango, N.S. Polyisoprenylated Methylated Protein Methylesterase: The Fulcrum of Chemopreventive Effects of NSAIDs and PUFAs. In Advances in Medicine and Biology; Berhardt, L.V., Ed.; Nova Science Publishers, Inc.: New York, NY, USA, 2013; pp. 119–144. [Google Scholar]
- Menter, D.G.; Schilsky, R.L.; DuBois, R.N. Cyclooxygenase-2 and cancer treatment: Understanding the risk should be worth the reward. Clin. Cancer Res. Off. J. Am. Assoc. Cancer Res. 2010, 16, 1384–1390. [Google Scholar] [CrossRef]
- Cheng, Y.; Austin, S.C.; Rocca, B.; Koller, B.H.; Coffman, T.M.; Grosser, T.; Lawson, J.A.; FitzGerald, G.A. Role of prostacyclin in the cardiovascular response to thromboxane A2. Science 2002, 296, 539–541. [Google Scholar] [CrossRef]
- Gurpinar, E.; Grizzle, W.E.; Piazza, G.A. NSAIDs inhibit tumorigenesis, but how? Clin. Cancer Res. Off. J. Am. Assoc. Cancer Res. 2014, 20, 1104–1113. [Google Scholar] [CrossRef]
- Miranda-Lara, C.A.; Ortiz, M.I.; Rodriguez-Ramos, F.; Chavez-Pina, A.E. Synergistic interaction between docosahexaenoic acid and diclofenac on inflammation, nociception, and gastric security models in rats. Drug Dev. Res. 2018, 79, 239–246. [Google Scholar] [CrossRef] [PubMed]
- Park, J.M.; Han, Y.M.; Jeong, M.; Kim, E.H.; Ko, W.J.; Cho, J.Y.; Hahm, K.B. Omega-3 polyunsaturated fatty acids as an angelus custos to rescue patients from NSAID-induced gastroduodenal damage. J. Gastroenterol. 2015, 50, 614–625. [Google Scholar] [CrossRef] [PubMed]
- Lucotti, S.; Cerutti, C.; Soyer, M.; Gil-Bernabe, A.M.; Gomes, A.L.; Allen, P.D.; Smart, S.; Markelc, B.; Watson, K.; Armstrong, P.C.; et al. Aspirin blocks formation of metastatic intravascular niches by inhibiting platelet-derived COX-1/thromboxane A2. J. Clin. Investig. 2019, 129, 1845–1862. [Google Scholar] [CrossRef] [PubMed]
- Sobolewski, C.; Cerella, C.; Dicato, M.; Ghibelli, L.; Diederich, M. The role of cyclooxygenase-2 in cell proliferation and cell death in human malignancies. Int. J. Cell Biol. 2010, 2010, 215158. [Google Scholar] [CrossRef] [PubMed]
- Tan, L.; Cho, K.J.; Neupane, P.; Capon, R.J.; Hancock, J.F. An oxanthroquinone derivative that disrupts RAS plasma membrane localization inhibits cancer cell growth. J. Biol. Chem. 2018. [Google Scholar] [CrossRef] [PubMed]
- Hall, A.; Nobes, C.D. Rho GTPases: Molecular switches that control the organization and dynamics of the actin cytoskeleton. Philos Trans. R Soc. Lond B Biol Sci 2000, 355, 965–970. [Google Scholar] [CrossRef]
- Cox, A.D.; Der, C.J.; Philips, M.R. Targeting RAS Membrane Association: Back to the Future for Anti-RAS Drug Discovery? Clin. Cancer Res. Off. J. Am. Assoc. Cancer Res. 2015, 21, 1819–1827. [Google Scholar] [CrossRef]
- Adjei, A.A. K-ras as a target for lung cancer therapy. J. Thorac. Oncol. Off. Publ. Int. Assoc. Study Lung Cancer 2008, 3, S160–S163. [Google Scholar] [CrossRef]
- Hobbs, G.A.; Der, C.J.; Rossman, K.L. RAS isoforms and mutations in cancer at a glance. J. Cell Sci. 2016, 129, 1287–1292. [Google Scholar] [CrossRef]
- Seo, J.; Barhoumi, R.; Johnson, A.E.; Lupton, J.R.; Chapkin, R.S. Docosahexaenoic acid selectively inhibits plasma membrane targeting of lipidated proteins. Faseb J. Off. Publ. Fed. Am. Soc. Exp. Biol. 2006, 20, 770–772. [Google Scholar] [CrossRef] [PubMed]
- Park, M.; Lim, J.W.; Kim, H. Docoxahexaenoic Acid Induces Apoptosis of Pancreatic Cancer Cells by Suppressing Activation of STAT3 and NF-kappaB. Nutrients 2018, 10, 1621. [Google Scholar] [CrossRef] [PubMed]
- Pfannschmidt, J. Editorial on "Long-term survival outcome after postoperative recurrence of non-small cell lung cancer: Who is ‘cured’ from postoperative recurrence?". J. Thorac. Dis. 2018, 10, 610–613. [Google Scholar] [CrossRef] [PubMed]
- Amissah, F.; Duverna, R.; Aguilar, B.J.; Poku, R.A.; Kiros, G.E.; Lamango, N.S. Polyisoprenylated methylated protein methyl esterase overexpression and hyperactivity promotes lung cancer progression. Am. J. Cancer Res. 2014, 4, 116–134. [Google Scholar] [PubMed]

| Cell Line | IC50 of DHA (µM) | ||||
|---|---|---|---|---|---|
| NSAID | DHA Alone | DHA + NSAID | |||
| 25 µM | 50 µM | 100 µM | |||
| NCI-H1573 | Diclofenac | 9.5 ± 1.3 | 4.5 ± 0.4 | 3.2 ± 0.4 | 3.0 ± 0.3 |
| Piroxicam | 9.5 ± 0.6 | ~9.8 | 10.1 ± 1.3 | 8.3 ± 0.2 | |
| Indomethacin | ~10.3 | 7.0 ± 0.2 | 7.0 ± 0.3 | 6.1 ± 0.1 | |
| Naproxen | ~10.0 | ~9.8 | 11.3 ± 0.4 | 10.0 ± 0.3 | |
| A549 | Diclofenac | 9.5 ± 1.1 | 4.3 ± 0.3 | 4.0 ± 0.3 | 3.7 ± 0.4 |
| Piroxicam | 9.0 ± 1.5 | 4.9 ± 1.1 | 5.0 ± 0.6 | 5.3 ± 0.7 | |
| Indomethacin | 10.3 ± 0.1 | 5.8 ± 0.1 | 5.7 ± 0.0 | 5.5 ± 0.1 | |
| Naproxen | 9.4 ± 0.8 | 5.9 ± 0.6 | 7.3 ± 0.1 | 6.4 ± 0.2 | |
| NCI-H1299 | Diclofenac | 9.8 ± 0.3 | 10.4 ± 0.4 | 11.3 ± 0.2 | 8.5 ± 0.5 |
| Piroxicam | 10.2 ± 0.5 | 9.7 ± 0.2 | 8.7 ± 0.4 | 8.4 ± 0.1 | |
| Indomethacin | 9.1 ± 0.1 | 5.9 ± 0.0 | 4.9 ± 0.3 | 3.1 ± 0.3 | |
| NCI-H1975 | Diclofenac | ~11.2 | ~11.2 | 7.3 ± 0.4 | 5.8 ± 0.3 |
| Piroxicam | 10.0 ± 1.0 | ~10.0 | 8.8 ± 0.1 | 8.2 ± 0.2 | |
| Indomethacin | 11.9 ± 0.8 | 9.7 ± 0.6 | 9.2 ± 0.1 | 8.0 ± 0.2 | |
| Naproxen | 9.8 ± 0.2 | 8.1 ± 0.3 | 9.6 ± 0.3 | 9.2 ± 0.3 | |
| Cell Line | IC50 of Diclofenac (µM) | |||
|---|---|---|---|---|
| Diclofenac Alone | Diclofenac + DHA | |||
| 2 µM | 5 µM | 10 µM | ||
| NCI-H1573 | 87.5 ± 9.6 | 71.4 ± 9.0 | 48.3 ± 1.4 | 25.0 ± 3.4 |
| A549 | 92.8 ± 9.9 | 83.1 ± 4.3 | 73.5± 6.5 | 11.3 ± 3.5 |
© 2020 by the authors. Licensee MDPI, Basel, Switzerland. This article is an open access article distributed under the terms and conditions of the Creative Commons Attribution (CC BY) license (http://creativecommons.org/licenses/by/4.0/).
Share and Cite
Poku, R.A.; Jones, K.J.; Van Baren, M.; Alan, J.K.; Amissah, F. Diclofenac Enhances Docosahexaenoic Acid-Induced Apoptosis in Vitro in Lung Cancer Cells. Cancers 2020, 12, 2683. https://doi.org/10.3390/cancers12092683
Poku RA, Jones KJ, Van Baren M, Alan JK, Amissah F. Diclofenac Enhances Docosahexaenoic Acid-Induced Apoptosis in Vitro in Lung Cancer Cells. Cancers. 2020; 12(9):2683. https://doi.org/10.3390/cancers12092683
Chicago/Turabian StylePoku, Rosemary A., Kylee J. Jones, Megan Van Baren, Jamie K. Alan, and Felix Amissah. 2020. "Diclofenac Enhances Docosahexaenoic Acid-Induced Apoptosis in Vitro in Lung Cancer Cells" Cancers 12, no. 9: 2683. https://doi.org/10.3390/cancers12092683
APA StylePoku, R. A., Jones, K. J., Van Baren, M., Alan, J. K., & Amissah, F. (2020). Diclofenac Enhances Docosahexaenoic Acid-Induced Apoptosis in Vitro in Lung Cancer Cells. Cancers, 12(9), 2683. https://doi.org/10.3390/cancers12092683

